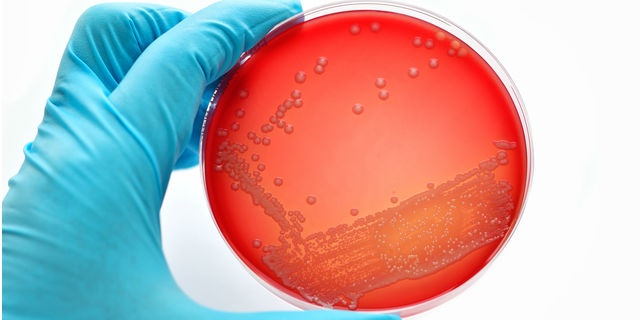
「Doctors Me（ドクターズミー）」コラム画像

《人喰いバクテリア》手足が壊死することも…症状と感染源について
人喰いバクテリアという言葉を聞いたことはありますか? 2015年には日本でも前年を大きく上回る感染数がニュースになっていたので、覚えていらっしゃる方もいるかもしれません。
今回は人喰いバクテリアについて特集してみたいと思います。
要チェック項目
□人喰いバクテリアは劇症型溶血性レンサ球菌感染症のこと
□溶連菌感染症とはレンサ球菌のタイプが異なる
□重症化しやすいため可及的速やかに治療を開始する必要がある人喰いバクテリアとは人喰いバクテリアというのはもちろん俗称で、医学的には「劇症型溶血性レンサ球菌感染症」と呼ばれる疾患のことをいいます。
メディアなどで人喰いバクテリアなどとセンセーショナルな取り上げ方をされるのでご存知の方も多いかもしれません。
溶連菌感染症との違い
子供に多く見られる疾患に溶連菌感染症というものがあります。正確には「A群β溶血性連鎖球菌感染症」といいますが、通常は咽頭炎を起こす程度の疾患です。
ただ、稀に血液や筋肉、肺などにレンサ球菌が侵入し、重篤化することがあります。
歴史
劇症型溶血性レンサ球菌感染症は1987年にアメリカで初めて報告された疾患で、その後、ヨーロッパやアジア圏でも発症が報告されています。日本では1992年に典型的な症例が初めて見られたということです。
患者数
劇症型溶血性レンサ球菌感染症を発症するのは毎年100人から200人程度と言われています。人喰いバクテリアと言われる所以はその致死率の高さで、全体の30%程度が死に至るということです。
どんな人がなりやすい?
通常の溶連菌感染所が幼児を中心に発症するのに対して、劇症型溶血性レンサ球菌感染症の場合は、特に30歳以降の大人に多く見られるのが特徴であるということです。劇症型溶血性レンサ球菌感染症の原因と感染源劇症型溶血性レンサ球菌感染症の原因は、連鎖球菌が通常なら侵入しないはずの血液や筋肉、肺などに侵入することです。
また、劇症型溶血性レンサ球菌感染症に罹った人に接触することによって感染するということです。劇症型溶血性レンサ球菌感染症の症状前駆症状
劇症型溶血性レンサ球菌感染症に感染すると、痛みが現れる前に発熱や悪寒、筋肉痛や下痢といった、インフルエンザの様な症状が患者さん全体の20%に見られるということです。
初期症状
劇症型溶血性レンサ球菌感染症の初期症状として最も一般的なのは、急激に始まる疼痛(うずくような痛み)であり、しかも痛み方がひどいのが特徴ということです。
また、鼻水や喉の痛み、咳やだるさを訴える患者もいるということです。
後発症状
急激に始まる疼痛に続いて、圧痛や全身症状が見られるようになります。
全身症状としては発熱が最も多いのですが、患者全体の10%に低体温が見られることもあるということで、その場合にはショック症状が疑われることとなります。
圧痛が見られる場合には、局所的に腫れやむくみが現れていることが多く、場合によっては水ぶくれが出来ることもあり、水ぶくれが破れて皮膚の糜爛(びらん、ただれること)が見られることもあるそうです。
さらに、患者さん全体の55%程度に昏睡状態や好戦的な態度をとるといった、錯乱状態が見られることもあるということです。
劇症型溶血性レンサ球菌感染症を発症すると、数十時間以内には軟部組織の壊死や急性腎不全、成人型呼吸窮迫症候群 、播種性血管内凝固症候群などが起こり始めます。
そして、多臓器不全を引き起こして、ショック状態から患者全体の30%程度が死に至るということです。最近では、妊産婦の症例も報告されているそうです。劇症型溶血性レンサ球菌感染症の治療薬物療法
劇症型溶血性レンサ球菌感染症の患者さんは、集中管理のもとで、抗菌剤による治療が行われます。
抗菌薬としてはペニシリン系の薬剤が第一選択薬であるということです。免疫グロブリン製剤の効果も報告されているということです。
輸液
血圧を維持するために、大量の輸液が行われる必要があるということです。ただ、輸液量の許容範囲が狭いため、肺動脈圧の数値に留意しながら輸液を行うことが必要とされます。
手術
軟部組織(筋肉や腱、靭帯)が壊死に至ってしまった場合には、放置すると腎不全や、代謝性アシドーシスの悪化を招いてしまうことがあります。
そのため、壊死を起こしている部分をなるべく広範囲にわたって切除し感染の拡大を防ぐことが重要となります。劇症型溶血性レンサ球菌感染症の予防法劇症型溶血性レンサ球菌感染症は傷口から感染することが多いので、まずは患部を清潔に保つことです。
その上で、風邪などを引いて免疫力が低下しないように気をつけましょう。また、手洗い・うがいをしっかりと行いましょう。
劇症型溶血性レンサ球菌感染症はまだまだ未解明な部分も多く、これといった予防法がないのが現状です。まずは病気に負けない体の状態を維持することが肝要です。おかしいなと思ったらすぐに病院へ! 劇症型溶血性レンサ球菌感染症は急激に、次々と、様々な症状が現れてくる疾患です。
「おかしいな」と思ったら、可及的速やかに医療機関を受診しましょう。
(監修:Doctors Me 医師)
今回は人喰いバクテリアについて特集してみたいと思います。
要チェック項目
□人喰いバクテリアは劇症型溶血性レンサ球菌感染症のこと
□溶連菌感染症とはレンサ球菌のタイプが異なる
□重症化しやすいため可及的速やかに治療を開始する必要がある人喰いバクテリアとは人喰いバクテリアというのはもちろん俗称で、医学的には「劇症型溶血性レンサ球菌感染症」と呼ばれる疾患のことをいいます。
メディアなどで人喰いバクテリアなどとセンセーショナルな取り上げ方をされるのでご存知の方も多いかもしれません。
溶連菌感染症との違い
子供に多く見られる疾患に溶連菌感染症というものがあります。正確には「A群β溶血性連鎖球菌感染症」といいますが、通常は咽頭炎を起こす程度の疾患です。
ただ、稀に血液や筋肉、肺などにレンサ球菌が侵入し、重篤化することがあります。
歴史
劇症型溶血性レンサ球菌感染症は1987年にアメリカで初めて報告された疾患で、その後、ヨーロッパやアジア圏でも発症が報告されています。日本では1992年に典型的な症例が初めて見られたということです。
患者数
劇症型溶血性レンサ球菌感染症を発症するのは毎年100人から200人程度と言われています。人喰いバクテリアと言われる所以はその致死率の高さで、全体の30%程度が死に至るということです。
どんな人がなりやすい?
通常の溶連菌感染所が幼児を中心に発症するのに対して、劇症型溶血性レンサ球菌感染症の場合は、特に30歳以降の大人に多く見られるのが特徴であるということです。劇症型溶血性レンサ球菌感染症の原因と感染源劇症型溶血性レンサ球菌感染症の原因は、連鎖球菌が通常なら侵入しないはずの血液や筋肉、肺などに侵入することです。
また、劇症型溶血性レンサ球菌感染症に罹った人に接触することによって感染するということです。劇症型溶血性レンサ球菌感染症の症状前駆症状
劇症型溶血性レンサ球菌感染症に感染すると、痛みが現れる前に発熱や悪寒、筋肉痛や下痢といった、インフルエンザの様な症状が患者さん全体の20%に見られるということです。
初期症状
劇症型溶血性レンサ球菌感染症の初期症状として最も一般的なのは、急激に始まる疼痛(うずくような痛み)であり、しかも痛み方がひどいのが特徴ということです。
また、鼻水や喉の痛み、咳やだるさを訴える患者もいるということです。
後発症状
急激に始まる疼痛に続いて、圧痛や全身症状が見られるようになります。
全身症状としては発熱が最も多いのですが、患者全体の10%に低体温が見られることもあるということで、その場合にはショック症状が疑われることとなります。
圧痛が見られる場合には、局所的に腫れやむくみが現れていることが多く、場合によっては水ぶくれが出来ることもあり、水ぶくれが破れて皮膚の糜爛(びらん、ただれること)が見られることもあるそうです。
さらに、患者さん全体の55%程度に昏睡状態や好戦的な態度をとるといった、錯乱状態が見られることもあるということです。
劇症型溶血性レンサ球菌感染症を発症すると、数十時間以内には軟部組織の壊死や急性腎不全、成人型呼吸窮迫症候群 、播種性血管内凝固症候群などが起こり始めます。
そして、多臓器不全を引き起こして、ショック状態から患者全体の30%程度が死に至るということです。最近では、妊産婦の症例も報告されているそうです。劇症型溶血性レンサ球菌感染症の治療薬物療法
劇症型溶血性レンサ球菌感染症の患者さんは、集中管理のもとで、抗菌剤による治療が行われます。
抗菌薬としてはペニシリン系の薬剤が第一選択薬であるということです。免疫グロブリン製剤の効果も報告されているということです。
輸液
血圧を維持するために、大量の輸液が行われる必要があるということです。ただ、輸液量の許容範囲が狭いため、肺動脈圧の数値に留意しながら輸液を行うことが必要とされます。
手術
軟部組織(筋肉や腱、靭帯)が壊死に至ってしまった場合には、放置すると腎不全や、代謝性アシドーシスの悪化を招いてしまうことがあります。
そのため、壊死を起こしている部分をなるべく広範囲にわたって切除し感染の拡大を防ぐことが重要となります。劇症型溶血性レンサ球菌感染症の予防法劇症型溶血性レンサ球菌感染症は傷口から感染することが多いので、まずは患部を清潔に保つことです。
その上で、風邪などを引いて免疫力が低下しないように気をつけましょう。また、手洗い・うがいをしっかりと行いましょう。
劇症型溶血性レンサ球菌感染症はまだまだ未解明な部分も多く、これといった予防法がないのが現状です。まずは病気に負けない体の状態を維持することが肝要です。おかしいなと思ったらすぐに病院へ! 劇症型溶血性レンサ球菌感染症は急激に、次々と、様々な症状が現れてくる疾患です。
「おかしいな」と思ったら、可及的速やかに医療機関を受診しましょう。
(監修:Doctors Me 医師)













